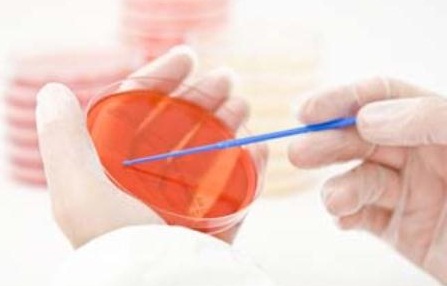
Анализ на грибковую микрофлору

Влияние антибиотиков

Антибиотики всасываются в кровь, проникая во внутренние органы и системы. Это снижает уровень палочек Додерляйна в области влагалища, которые контролируют уровень полезной микрофлоры. Так происходит развитие вагинального кандидоза.
После курса антибиотиков у женщин часто наблюдается развитие молочницы, что связано с нарушением баланса микрофлоры. Врачи рекомендуют начинать лечение с пробиотиков, которые помогают восстановить нормальную флору влагалища. Также полезно использовать антимикотические препараты, такие как флуконазол, которые эффективно борются с грибами рода Candida. Важно помнить о необходимости соблюдения гигиенических норм и избегания раздражающих средств, таких как ароматизированные мыла и гели. Врачи подчеркивают, что консультация с гинекологом обязательна для выбора оптимальной схемы лечения, особенно если молочница повторяется. Правильный подход к восстановлению микрофлоры поможет избежать рецидивов и улучшить общее состояние здоровья.

Симптоматика на фоне антибиотиков
Как определить молочницу после антибиотиков у женщин? Необходимо обратить внимание на следующие симптомы и признаки:
- Развитие зуда и характерного жжения в районе гениталий.
- Усиление неприятных ощущений при мочеиспускании и сексе.
- Появление сливкоподобных и творожистообразных выделений, имеющих запах, который напоминает испорченную кисломолочную продукцию.
- Прогрессирование симптомов в предменструальный период.
Если после приема антибиотиков появились перечисленные выше симптомы, то необходимо проконсультироваться с врачом. Специалист проведет визуальный гинекологический осмотр и возьмет мазок для проведения лабораторного исследования микрофлоры. После получения результатов анализов лечащий врач назначит медикаментозную терапию.
Лечебные мероприятия
Если молочница у женщин возникла на фоне антибактериальной терапии, то в первую очередь рекомендовано обратиться к врачу, который откорректирует лечение. Самолечение может не дать должного результата, что станет причиной прогрессирования заболевания. К борьбе с дисбактериозом влагалища следует подходить комплексно. Лечебные меры должны быть направлены на восстановление полезной микрофлоры в области кишечника и влагалища. Для этого назначаются специальные лекарственные средства, для увеличения эффективности которых, женщина должна придерживаться специальной диеты: обогатить рацион кисломолочной продукцией натурального происхождения (йогурт, кефир, сыр) и исключить сладкое и мучное. Важно ежедневно употреблять овощи и фрукты, а также отказаться от курения и спиртных напитков.
Среди полезных продуктов питания следует выделить и те, которые в составе имеют пробиотики: овсянка, бананы и бобовые. В обязательном порядке нужно принять меры, направленные на укрепление защитных функций организма. Для того рекомендуется вести активный образ жизни, соблюдать режим сна и режим питания, ежедневно совершать пешие прогулки на свежем воздухе. При необходимости врач назначает иммуностимулирующие препараты, такие как экстракт Женьшеня и витаминно-минеральные комплексы.
Для достижения быстрого результата следует комплексно подходить к решению проблемы. При развитии молочницы, как правило, прекращается прием антибиотиков или же лекарства принимаются в комплексе со средствами, подавляющими развитие грибковой микрофлоры. Чтобы быстро восстановить нужный уровень pH, назначаются препараты местного и системного воздействия.
После курса антибиотиков многие женщины сталкиваются с неприятными последствиями, такими как молочница. В поисках решения этой проблемы они часто обращаются к рекомендациям знакомых и медицинским источникам. Одни советуют использовать пробиотики, которые помогают восстановить баланс микрофлоры, другие рекомендуют натуральные средства, такие как йогурт или чеснок. Некоторые женщины отмечают эффективность противогрибковых препаратов, которые можно приобрести в аптеке без рецепта. Однако важно помнить, что самолечение может усугубить ситуацию. Многие специалисты подчеркивают необходимость консультации с врачом, чтобы подобрать наиболее подходящее лечение и избежать рецидивов. В целом, опыт женщин разнообразен, и каждый находит свой путь к восстановлению здоровья.

Противогрибковая терапия
Чем лечить молочницу? Для подавления грибковой микрофлоры и восстановления микробиоценоза влагалищной среды нужно применять только эффективные и проверенные временем препараты. В самом начале прогрессирования грибковой инфекции можно обойтись лекарственными средствами, которые обладают местным, а не системным воздействием на организм: интравагинальными таблетками, суппозиториями, антимикотическими мазями и кремами.
Препараты, используемые для местного нанесения при вагинальной молочнице:
- «Пимафуцин» (натамицин). Оказывает угнетающее воздействие на грибок путем увеличения проницаемости клеточных мембран. Быстро останавливает рост грибкового мицелия и борется с клиническими проявлениями. Курс лечения составляет от 3 до 5 суток, что зависит от степени прогрессирования молочницы.
- «Ливарол» (кетоконазол). Быстродействующий препарат, эффективность которого направлена на подавление активности грибка в области влагалища. Лекарство выпускается в форме суппозиториев, которые следует закладывать на ночь для достижения более выраженного результата от проводимого лечения. Курс терапии длится от 3 до 5 суток.
- «Микосист» (флуконазол). Эффективные вагинальные таблетки, которые широко используются в борьбе с кандидозом влагалища, вызванным грибком рода Кандида. Препарат оказывает местное воздействие на возбудителя молочницы, что быстро устраняет симптоматику болезни и предотвращает прогрессирование грибкового мицелия. Курс лечения варьируется в зависимости от сложности заболевания: от 3 до 7 суток.
- «Клотримазол» (клотримазол). Таблетки предназначены для закладывания во влагалище. Лекарственный препарат обладает местным воздействием. С его помощью удается устранить грибковую микрофлору и восстановить поврежденные слизистые структуры влагалища. Терапия длится на протяжении 7-14 дней.
Длительность медикаментозной терапии зависит от клинической картины болезни. В среднем составляет 3-10 дней. Если после однократной медикаментозной терапии не наблюдается улучшений, то для устранения кандидоза назначаются противогрибковые средства, обладающие системным действием. В данном случае речь идет о сильнодействующих медикаментах, которые могут оказаться токсичными и спровоцировать развитие побочных реакций.
Обратите внимание: с помощью антибиотиков невозможно вылечить кандидоз. Такая терапия — предрасполагающий фактор для развития грибка. Именно поэтому при проведении антибактериальной терапии должны быть назначены лекарства, восстанавливающий естественный уровень pH влагалища.
Нормализация внутренней микрофлоры
После того как грибковая микрофлора будет устранена, нужно сдать контрольный анализ. Для исключения вероятности прогрессирования кандидоза, нужно нормализовать естественную микрофлору. При помощи препаратов удается уменьшить количество выделений и устранить неприятный запах. Данные меры помогают справиться с дискомфортом, который характерен для дисбактериоза влагалища: жжение и зуд при мочеиспускании, боли во время полового акта и т. п.
Своевременное лечение дисбактериоза влагалища, развивающегося на фоне грибкового поражения после антибактериальной терапии, позволяет предотвратить развитие таких осложнений, как инфицирование матки и придатков и поражение мочевого пузыря. При отсутствии своевременного лечения существуют риски развития цистита, нефрита, аднексита, эндометрита и пиелонефрита.
Коррекция местного иммунитета осуществляется с помощью следующих препаратов:
- «Экофемин». Вагинальный пробиотик, назначаемый для нормализации баланса полезных микроорганизмов в области влагалища. В его состав входят лактобактерии, которые восстанавливают верхний слой эпителия и препятствует его слущиванию. Препарат достаточно быстро нормализует флору влагалища и предотвращает прогрессирование грибкового мицелия. Курс лечения составляет 5-7 дней.
«Вагинорм С». Вагинальные таблетки, нормализующие уровень полезной флоры в области влагалища. Широко используются для проведения коррекции после антибактериальной терапии. Препарат обладает двойным действием: заселяет полезные микроорганизмы и наращивает эпителий, что незаменимо для предотвращения развития рецидивов. Курс лечения длится 7 дней.
- «Лактобактерин». Суппозитории широко используются для восстановления влагалищной микрофлоры после лечения антибиотиками. Лекарственное средство быстро устраняет симптоматику молочницы и нормализует баланс полезных микроорганизмов во внутренней среде организма. Курс лечения составляет 10 суток.
После приема антибиотиков нельзя заниматься самолечением для устранения таких последствий, как молочница. Средства для восстановления микрофлоры должен назначать врач после проведения комплексного обследования. Эти препараты не являются опасными, но, несмотря на это после приёма больших дозировок могут развиться побочные реакции в виде аллергии и ухудшения самочувствия.
Советы народной медицины
Медикаментозные препараты можно использовать вкупе с народными средствами. После приёма антибиотиков комплексное воздействие помогает восстановиться гораздо быстрее. Вылечить дисбактериоз влагалища можно с помощью следующих рецептов:
- Фито-тампоны. Для изготовления понадобится вата и марля. Вату следует пропитать кефиром или медом, и плотно закрутить марлей, предварительно сделав из нее небольшой шнурок и вложив его внутрь. Курс лечения составляет 10 дней. Процедуру закладывания следует проводить на ночь.
- Облепиховое масло. На его основе следует готовить раствор для спринцевания или же пропитывать маслом самодельные тампоны. Курс лечения составляет 10 дней.
- Ромашка аптечная. Для приготовления настоя понадобится 1 ст. л. сухой травы и 200 мл кипятка. Раствор используется для спринцевания. Процедура проводится 1-2 раза в день, на протяжении 10 суток.
Нетрадиционное лечение – отличная вспомогательная мера, которая широко применяется для нормализации микрофлоры, которая нарушается при приеме антибактериальных препаратов. Использование таких мер без предварительной консультации с врачом может не дать должного результата. Народная терапия эффективна только вкупе с медикаментозными препаратами.
Молочница от антибиотиков – опасное состояние организма, которое создает в организме женщины хорошую среду для развития грибка и присоединения бактериальной микрофлоры. После развития клинической картины кандидоза следует обратиться к опытному специалисту, который назначит диагностику и медикаментозную коррекцию при необходимости.
https://youtube.com/watch?v=xbCVBsd7eRg
Вопрос-ответ
Каковы основные симптомы молочницы после курса антибиотиков?
Симптомы молочницы могут включать зуд и жжение в области влагалища, белые творожистые выделения, а также болезненные ощущения при половом акте. Если вы заметили эти симптомы после приема антибиотиков, стоит обратиться к врачу для подтверждения диагноза.
Какие препараты могут помочь в лечении молочницы после антибиотиков?
Для лечения молочницы часто применяются противогрибковые препараты, такие как флуконазол или клотримазол. Также могут быть рекомендованы пробиотики для восстановления нормальной микрофлоры. Важно проконсультироваться с врачом перед началом лечения.
Как предотвратить развитие молочницы после приема антибиотиков?
Для предотвращения молочницы рекомендуется принимать пробиотики во время и после курса антибиотиков, соблюдать правила личной гигиены и избегать использования агрессивных моющих средств. Также полезно поддерживать иммунную систему с помощью сбалансированного питания и достаточного количества отдыха.
Советы
СОВЕТ №1
Используйте пробиотики. После курса антибиотиков важно восстановить баланс микрофлоры. Пробиотики, содержащие живые бактерии, могут помочь в этом. Выбирайте продукты, богатые пробиотиками, такие как йогурт, кефир или специальные добавки.
СОВЕТ №2
Соблюдайте гигиену. Поддерживайте интимную гигиену, используя мягкие, неароматизированные средства для мытья. Избегайте синтетического нижнего белья и старайтесь носить хлопковые трусики, чтобы обеспечить хорошую вентиляцию.
СОВЕТ №3
Обратите внимание на питание. Увеличьте потребление продуктов, богатых витаминами и минералами, особенно витамина C и цинка. Ограничьте сахар и углеводы, так как они могут способствовать росту грибков.
СОВЕТ №4
Консультируйтесь с врачом. Если симптомы молочницы не проходят или усиливаются, обязательно обратитесь к врачу. Он может назначить подходящее лечение, включая противогрибковые препараты, которые помогут справиться с инфекцией.

«Вагинорм С». Вагинальные таблетки, нормализующие уровень полезной флоры в области влагалища. Широко используются для проведения коррекции после антибактериальной терапии. Препарат обладает двойным действием: заселяет полезные микроорганизмы и наращивает эпителий, что незаменимо для предотвращения развития рецидивов. Курс лечения длится 7 дней.
